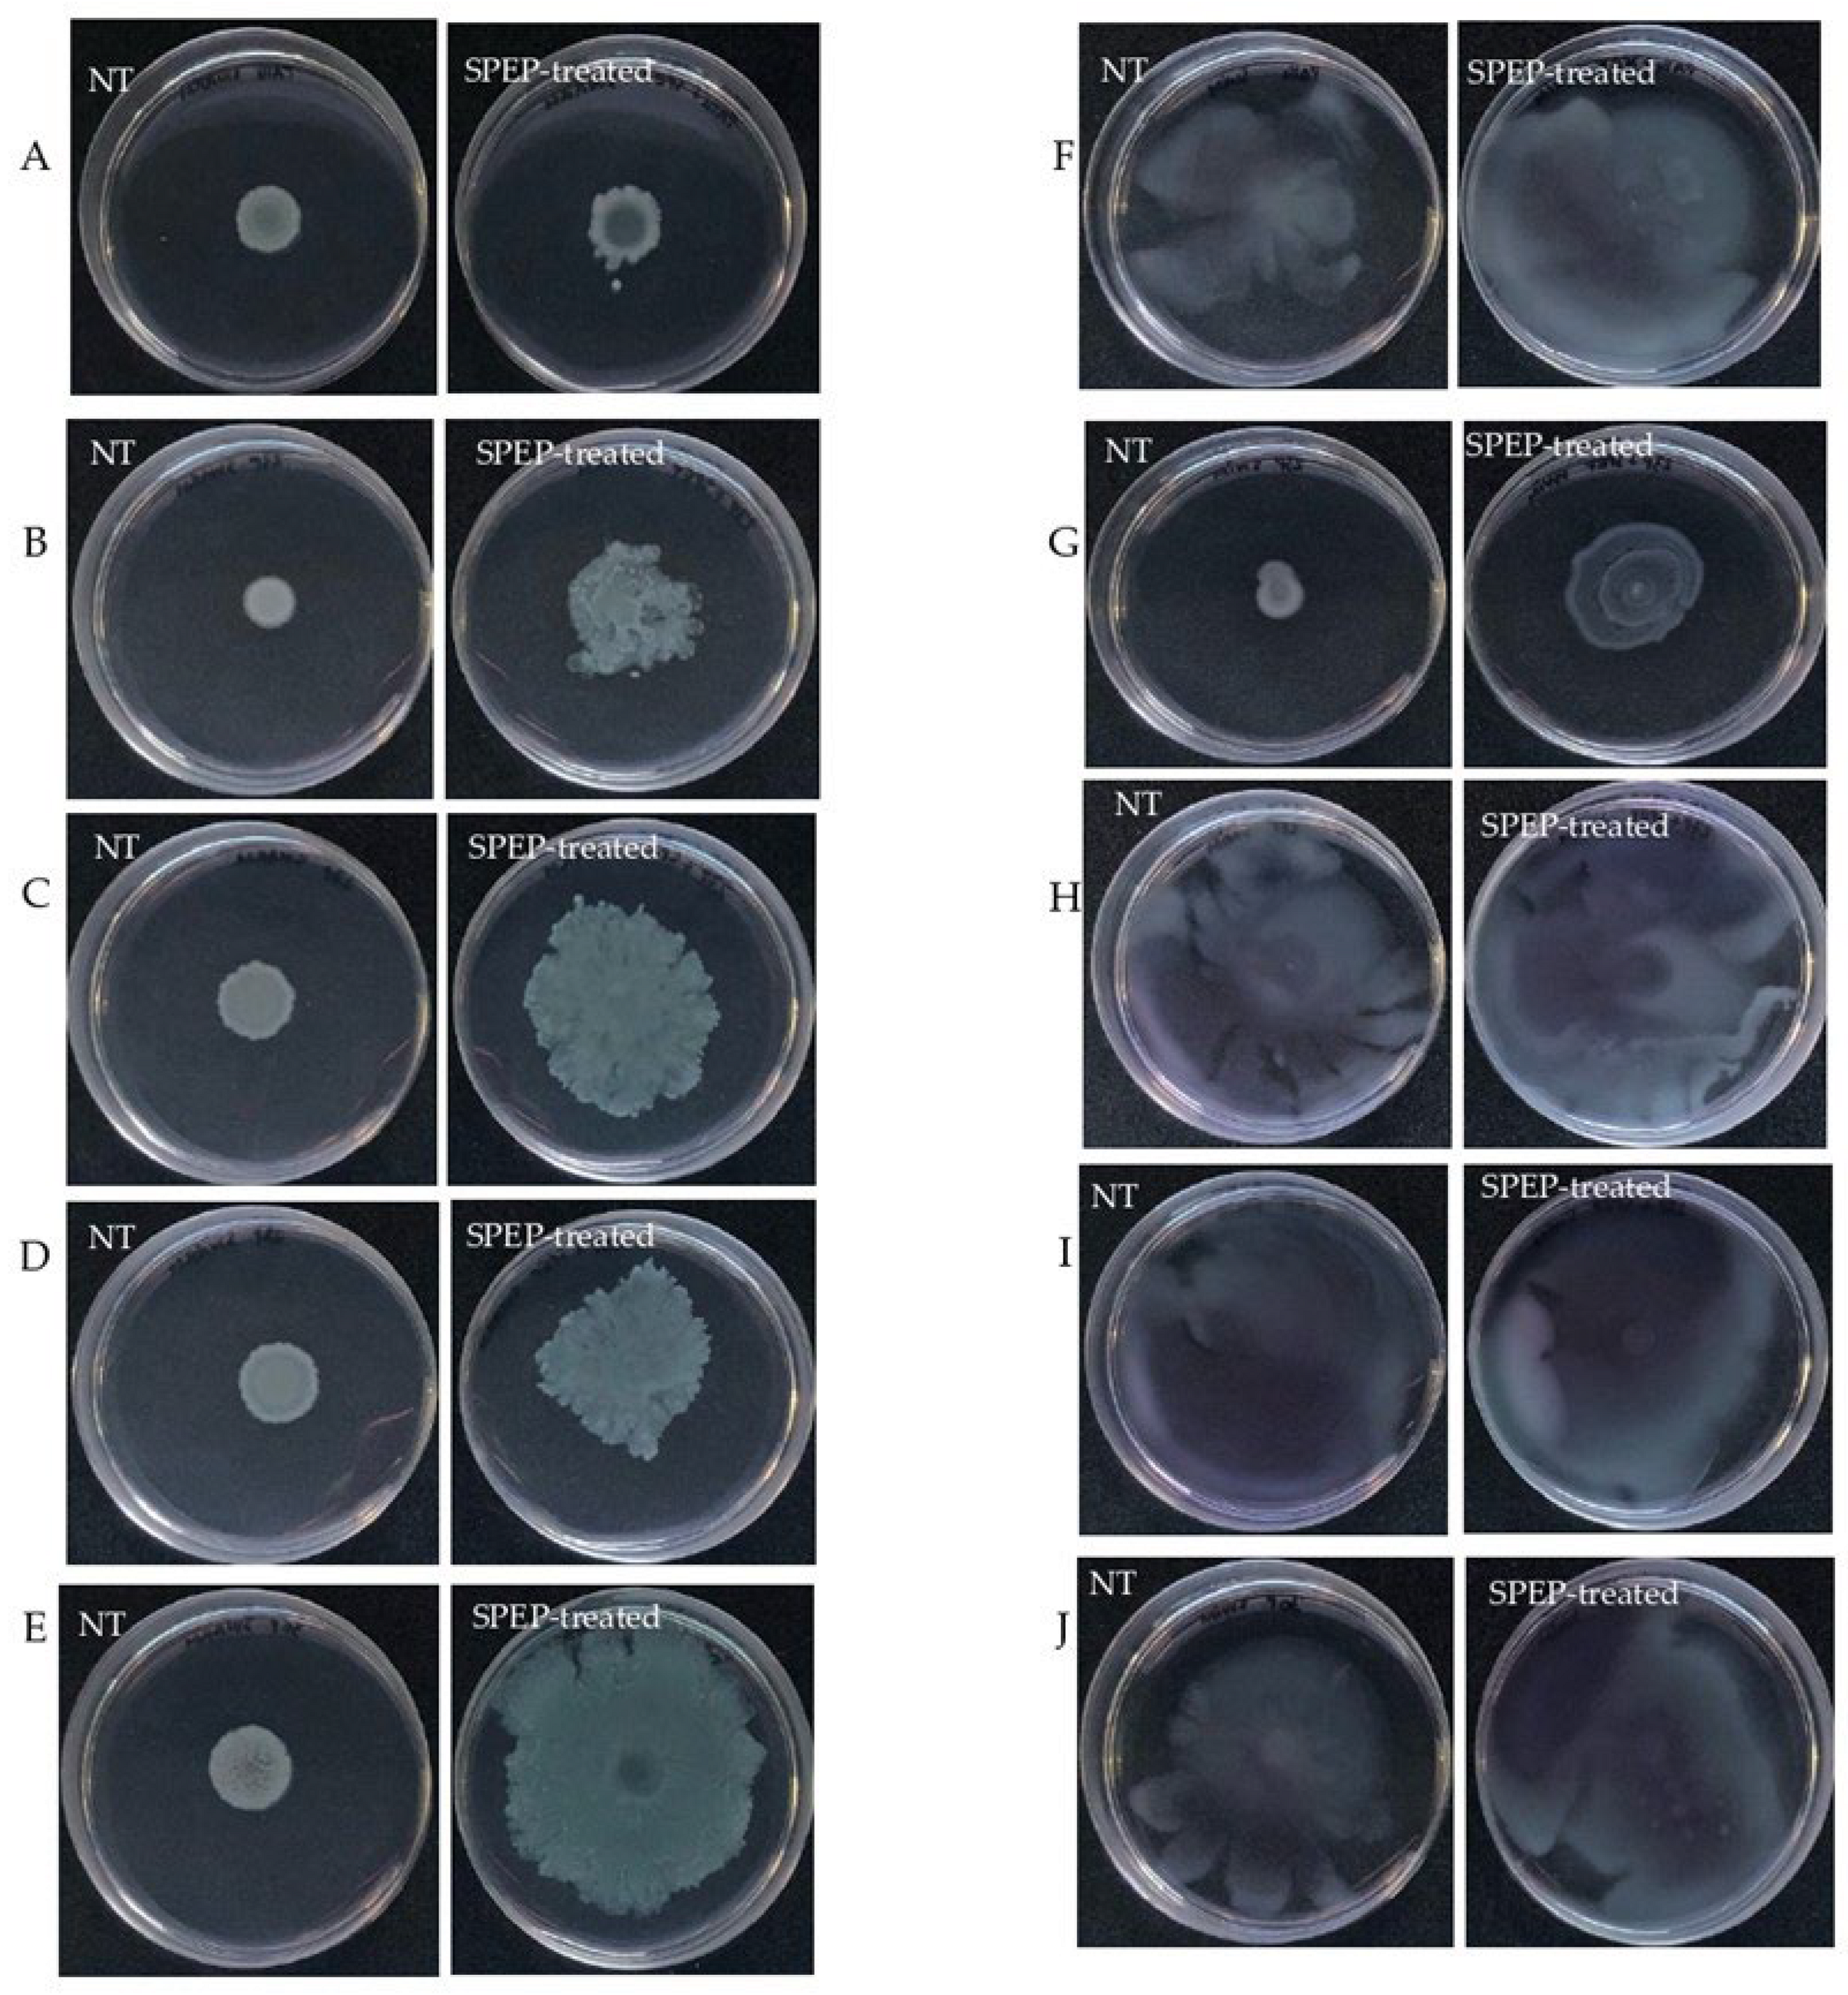
Ijms 23 12645 g006 Ijms 23 12645 g006

Serratiopeptidase Affects the Physiology of Pseudomonas aeruginosa Isolates from Cystic Fibrosis Patients
Abstract
1. Introduction
2. Results
2.1. Effect of SPEP on Biofilm Formation
2.2. Effect of SPEP on Pyocyanin and Pyoverdine Production
2.3. Effect of SPEP on Motility of P. aeruginosa
2.4. Effect of SPEP on Staphylolytic Activity of P. aeruginosa
2.5. Effect of SPEP on Adhesion and Invasion of P. aeruginosa to Eukaryotic Cells
3. Discussion
4. Materials and Methods
4.1. Ethics Approval and Informed Consent
4.2. Chemicals
4.3. Bacterial Strains and Growth Conditions
4.4. Biofilm Formation
4.5. Mature Biofilm
4.6. Pyocyanin Assay
4.7. Pyoverdine Assay
4.8. Motility Assays
4.8.1. Swarming Assay
4.8.2. Swimming Assay
4.9. Disk Diffusion Staphylolysin Susceptibility Assay
4.10. Eukaryotic Cells
4.11. Gentamicin Toxicity Assay on A549 Cells
4.12. Antibiotic Protection Assay
Supplementary Materials
Author Contributions
Funding
Institutional Review Board Statement
Informed Consent Statement
Conflicts of Interest
References
- Rimessi, A.; Vitto, V.A.M.; Patergnani, S.; Pinton, P. Update on Calcium signaling in cystic fibrosis lung disease. Front. Pharmacol. 2021, 12, 581645. [Google Scholar] [CrossRef] [PubMed]
- Rosales-Reyes, R.; Vargas-Roldán, S.Y.; Lezana-Fernández, J.L.; Santos-Preciado, J.I. Pseudomonas aeruginosa: Genetic adaptation, a strategy for its persistence in cystic fibrosis. Arch. Med. Res. 2020, S0188–S4409, 32245–32251. [Google Scholar] [CrossRef] [PubMed]
- O’Sullivan, B.P.; Freedman, S.D. Cystic fibrosis. Lancet 2009, 373, 1891–1904. [Google Scholar] [CrossRef]
- Sousa, A.M.; Pereira, M.O. Pseudomonas aeruginosa diversification during infection development in cystic fibrosis Lungs-A review. Pathogens 2014, 3, 680–703. [Google Scholar] [CrossRef]
- Pendleton, J.N.; Gorman, S.P.; Gilmore, B.F. Clinical relevance of the ESKAPE pathogens. Expert Rev. Anti-Infect. Ther. 2013, 11, 297–308. [Google Scholar] [CrossRef] [PubMed]
- Winstanley, C.; O’Brien, S.; Brockhurst, M.A. Pseudomonas aeruginosa evolutionary adaptation and diversification in cystic fibrosis chronic lung infections. Trends Microbiol. 2016, 24, 327–337. [Google Scholar] [CrossRef]
- Hentzer, M.; Givskov, M. Pharmacological inhibition of quorum sensing for the treatment of chronic bacterial infections. J. Clin. Invest. 2003, 112, 1300–1307. [Google Scholar] [CrossRef] [PubMed]
- Rasko, D.A.; Sperandio, V. Anti-virulence strategies to combat bacteria-mediated disease. Nat. Rev. Drug Discov. 2010, 9, 117–128. [Google Scholar] [CrossRef]
- Koh, C.L.; Sam, C.K.; Yin, W.F.; Tan, L.Y.; Krishnan, T.; Chong, Y.M.; Chan, K.G. Plant-derived natural products as sources of anti-quorum sensing compounds. Sensors 2013, 13, 6217–6228. [Google Scholar] [CrossRef]
- Papa, R.; Selan, L.; Parrilli, E.; Tilotta, M.; Sannino, F.; Feller, G.; Tutino, M.L.; Artini, M. Anti-biofilm activities from marine cold adapted bacteria against Staphylococci and Pseudomonas aeruginosa. Front. Microbiol. 2015, 6, 1333. [Google Scholar] [CrossRef]
- Ceylan, O.; Sahin, M.; Akdamar, G. Antioxidant and anti-quorum sensing potential of Acer monspessulanum subsp. mon-spessulanum extracts. Planta Med. 2016, 82, 1335–1340. [Google Scholar]
- Pattnaik, S.; Ahmed, T.; Ranganathan, S.K.; Ampasala, D.R.; Sarma, V.V.; Busi, S. Aspergillus ochraceopetaliformis SSP13 modulates quorum sensing regulated virulence and biofilm formation in Pseudomonas aeruginosa PAO1. Biofouling 2018, 34, 410–425. [Google Scholar] [CrossRef] [PubMed]
- Elmanama, A.A.; Al-Reefi, M.R. Antimicrobial, anti-biofilm, anti- quorum sensing, antifungal and synergistic effects of some medicinal plants extracts. IUG J. Nat. Eng. Stud. 2017, 25, 198–207. [Google Scholar]
- Jadhav, S.B.; Shah, N.; Rathi, A.; Rathi, V.; Rathi, A. Serratiopeptidase: Insights into the therapeutic applications. Biotechnol. Rep. 2020, 28, e00544. [Google Scholar] [CrossRef] [PubMed]
- Tiwari, M. The role of serratiopeptidase in the resolution of inflammation. Asian J. Pharm. Sci. 2017, 12, 209–215. [Google Scholar] [CrossRef] [PubMed]
- Saggu, S.K.; Jha, G.; Mishra, P.C. Enzymatic degradation of biofilm by metalloprotease from Microbacterium sp. SKS10. Front. Bioeng. Biotech. 2019, 7, 192. [Google Scholar] [CrossRef] [PubMed]
- Molobela, I.P.; Cloete, T.E.; Beukes, M. Protease and amylase enzymes for biofilm removal and degradation of extracellular polymeric substances (EPS) produced by Pseudomonas fluorescens bacteria. Afr. J. Microbiol. Res. 2010, 4, 1515–1524. [Google Scholar]
- Elchinger, P.H.; Delattre, C.; Faure, S.; Roy, O.; Badel, S.; Bernardi, T.; Taillefumier, T.; Michaud, P. Effect of proteases against biofilms of Staphylococcus aureus and Staphylococcus epidermidis. Lett. Appl. Microbiol. 2014, 59, 507–513. [Google Scholar] [CrossRef]
- Santhosh, K. The emerging role of serratiopeptidase in oral surgery: Literature update. Asian J. Clin. Pharm. Res. 2018, 11, 19–23. [Google Scholar]
- Ethiraj, S.; Gopinath, S. Production, purification, characterization, immobilization, and application of Serrapeptase: A review. Front. Biol. 2017, 12, 333–348. [Google Scholar] [CrossRef]
- Passariello, C.; Lucchese, A.; Pera, F.; Gigola, P. Clinical, microbiological and inflammatory evidence of the efficacy of combination therapy including serratiopeptidase in the treatment of periimplantitis. Eur. J. Inflam. 2012, 10, 463–472. [Google Scholar] [CrossRef]
- Artini, M.; Papa, R.; Scoarughi, G.L.; Galano, E.; Barbato, G.; Pucci, P.; Selan, L. Comparison of the action of different proteases on virulence properties related to the staphylococcal surface. J. Appl. Microbiol. 2013, 114, 266–277. [Google Scholar] [CrossRef] [PubMed]
- Papa, R.; Artini, M.; Cellini, A.; Tilotta, M.; Galano, E.; Pucci, P.; Amoresano, A.; Selan, L. A new anti-infective strategy to reduce the spreading of antibiotic resistance by the action on adhesion-mediated virulence factors in Staphylococcus aureus. Microb. Pathog. 2013, 63, 44–53. [Google Scholar] [CrossRef]
- Selan, L.; Papa, R.; Ermocida, A.; Cellini, A.; Ettorre, E.; Vrenna, G.; Campoccia, D.; Montanaro, L.; Arciola, C.R.; Artini, M. Serratiopeptidase reduces the invasion of osteoblasts by Staphylococcus aureus. Int. J. Immunopathol. Pharmacol. 2017, 30, 423–428. [Google Scholar] [CrossRef] [PubMed]
- Selan, L.; Berlutti, F.; Passariello, C.; Comodi-Ballanti, M.R.; Thaller, M.C. Proteolytic enzymes: A new treatment strategy for prosthetic infections? Antimicrob. Agents Chemother. 1993, 37, 2618–2621. [Google Scholar] [CrossRef] [PubMed]
- Zhou, J.; Bi, S.; Chen, H.; Chen, T.; Yang, R.; Li, M.; Fu, Y.; Jia, A.Q. Anti-biofilm and antivirulence activities of metabolites from Plectosphaerella cucumerina against Pseudomonas aeruginosa. Front. Microbiol. 2017, 8, 769. [Google Scholar] [CrossRef] [PubMed]
- Díaz-Pérez, S.P.; Solis, C.S.; López-Bucio, J.S.; Valdez Alarcón, J.J.; Villegas, J.; Reyes-De la Cruz, H.; Campos-Garcia, J. Pathogenesis in Pseudomonas aeruginosa PAO1 Biofilm-Associated Is Dependent on the Pyoverdine and Pyocyanin Siderophores by Quorum Sensing Modulation. Microb. Ecol. 2022; epub ahead of print. [Google Scholar]
- Gellatly, S.L.; Hancock, R.E. Pseudomonas aeruginosa: New insights into pathogenesis and host defenses. Pathog. Dis. 2013, 67, 159–173. [Google Scholar] [CrossRef]
- Lau, G.W.; Hassett, D.J.; Ran, H.; Kong, F. The role of pyocyanin in Pseudomonas aeruginosa infection. Trends Mol. Med. 2004, 10, 599–606. [Google Scholar] [CrossRef]
- Kessler, E.; Safrin, M. Elastinolytic and proteolytic enzymes. Methods Mol. Biol. 2014, 1149, 135–169. [Google Scholar] [PubMed]
- Mikkelsen, H.; McMullan, R.; Filloux, A. The Pseudomonas aeruginosa reference strain PA14 displays increased virulence due to a mutation in ladS. PLoS ONE 2011, 6, e29113. [Google Scholar] [CrossRef]
- Parrilli, E.; Papa, R.; Carillo, S.; Tilotta, M.; Casillo, A.; Sannino, F.; Cellini, A.; Artini, M.; Selan, L.; Corsaro, M.M.; et al. Anti-biofilm activity of Pseudoalteromonas haloplanktis TAC125 against Staphylococcus epidermidis biofilm: Evidence of a signal molecule involvement? Int. J. Immunopathol. Pharmacol. 2015, 28, 104–113. [Google Scholar] [CrossRef]
- Mahenthiralingam, E.; Campbell, M.E.; Speert, D.P. Nonmotility and phagocytic resistance of Pseudomonas aeruginosa isolates from chronically colonized patients with cystic fibrosis. Infect. Immun. 1994, 62, 596–605. [Google Scholar] [CrossRef] [PubMed]
- Kašparová, P.; Vaňková, E.; Paldrychová, M.; Svobodová, A.; Hadravová, R.; Jarošová Kolouchová, I.; Masák, J.; Scholtz, V. Non-thermal plasma causes Pseudomonas aeruginosa biofilm release to planktonic form and inhibits production of Las-B elastase, protease and pyocyanin. Front. Cell. Infect. Microbiol. 2022, 12, 993029. [Google Scholar] [CrossRef] [PubMed]
- Suo, A.; Hua, Z.; Wu, C.; Fan, G.; Li, T.; Cong, K. Effects of ginkgolic acid(C15:1) on biofilm formation, pathogenic factor production and quorum sensing of Pseudomonas aeruginosa. Microb. Pathog. 2022, 173, 105813. [Google Scholar] [CrossRef] [PubMed]
- Ragno, R.; Papa, R.; Patsilinakos, A.; Vrenna, G.; Garzoli, S.; Tuccio, V.; Fiscarelli, E.; Selan, L.; Artini, M. Essential oils against bacterial isolates from cystic fibrosis patients by means of antimicrobial and unsupervised machine learning approaches. Sci. Rep. 2020, 10, 2653. [Google Scholar] [CrossRef]
- Wilderman, P.J.; Vasil, A.I.; Johnson, Z.; Wilson, M.J.; Cunliffe, H.E.; Lamont, I.L.; Vasil, M.L. Characterization of an endoprotease (PrpL) encoded by a PvdS-regulated gene in Pseudomonas aeruginosa. Infect. Immun. 2001, 69, 5385–5394. [Google Scholar] [CrossRef]
- Artini, M.; Papa, R.; Sapienza, F.; Božović, M.; Vrenna, G.; Tuccio Guarna Assanti, V.; Sabatino, M.; Garzoli, S.; Fiscarelli, E.V.; Ragno, R.; et al. Essential Oils Biofilm Modulation Activity and Machine Learning Analysis on Pseudomonas aeruginosa Isolates from Cystic Fibrosis Patients. Microorganisms 2022, 10, 887. [Google Scholar] [CrossRef] [PubMed]
- Vrenna, G.; Artini, M.; Ragno, R.; Relucenti, M.; Fiscarelli, E.V.; Tuccio Guarna Assanti, V.; Papa, R.; Selan, L. Anti-Virulence Properties of Coridothymus capitatus Essential Oil against Pseudomonas aeruginosa Clinical Isolates from Cystic Fibrosis Patients. Microorganisms 2021, 9, 2257. [Google Scholar] [CrossRef]
- Pallett, R.; Leslie, L.J.; Lambert, P.A.; Milic, I.; Devitt, A.; Marshall, L.J. Anaerobiosis influences virulence properties of Pseudomonas aeruginosa cystic fibrosis isolates and the interaction with Staphylococcus aureus. Sci. Rep. 2019, 9, 6748. [Google Scholar] [CrossRef]
- Papa, R.; Vrenna, G.; D’Angelo, C.; Casillo, A.; Relucenti, M.; Donfrancesco, O.; Corsaro, M.M.; Fiscarelli, E.V.; Tuccio Guarna Assanti, V.; Tutino, M.L.; et al. Anti-Virulence Activity of the Cell-Free Supernatant of the Antarctic Bacterium Psychrobacter sp. TAE2020 against Pseudomonas aeruginosa Clinical Isolates from Cystic Fibrosis Patients. Antibiotics 2021, 10, 944. [Google Scholar] [CrossRef]

| Untreated | SPEP-Treated | |||
|---|---|---|---|---|
| Adhesion | Invasion | Adhesion | Invasion | |
| P. aeruginosa PA14 | 1.41 × 105 ± 0.08 × 105 | 2.82 × 103 ± 0.46 × 103 | 1.16 × 105 ± 0.21 × 105 | 2.0 × 101 ± 0.3 × 101 |
| P. aeruginosa 27P | 3.04 × 105 ± 0.21 × 105 | 3.20 × 103 ± 0.08 × 103 | 1.79 × 105 ± 0.45 × 105 | 3.0 × 101 ± 0.6 × 101 |
| Bacterial Strain | Pyocyanin (OD 520 nm) | Pyoverdine (OD 460/400 nm) | Biofilm 24 h a (OD 590 nm) | Biofilm 48 h b (OD 590 nm) |
|---|---|---|---|---|
| PA14 | 0.178 ± 0.042 | 1821 ± 19 | 3.561 ± 0.357 | 13.470 ± 1.403 |
| 23P | 0.148 ± 0.024 | Not producer | 3.175 ± 0.851 | 0.738 ± 0.373 |
| 27P | 0.102 ± 0.005 | 765 ± 11 | 1.429 ± 0.643 | 3.049 ± 0.796 |
| 28P | 0.093 ± 0.032 | 4871 ± 39 | 0.265 ± 0.038 | 2.540 ± 0.799 |
| 30P | 0.115 ± 0.022 | 23740 ± 372 | 0.866 ± 0.345 | 5.013 ± 1.391 |
Publisher’s Note: MDPI stays neutral with regard to jurisdictional claims in published maps and institutional affiliations. |
© 2022 by the authors. Licensee MDPI, Basel, Switzerland. This article is an open access article distributed under the terms and conditions of the Creative Commons Attribution (CC BY) license (https://creativecommons.org/licenses/by/4.0/).
Share and Cite
Artini, M.; Vrenna, G.; Trecca, M.; Tuccio Guarna Assanti, V.; Fiscarelli, E.V.; Papa, R.; Selan, L. Serratiopeptidase Affects the Physiology of Pseudomonas aeruginosa Isolates from Cystic Fibrosis Patients. Int. J. Mol. Sci. 2022, 23, 12645. https://doi.org/10.3390/ijms232012645
Artini M, Vrenna G, Trecca M, Tuccio Guarna Assanti V, Fiscarelli EV, Papa R, Selan L. Serratiopeptidase Affects the Physiology of Pseudomonas aeruginosa Isolates from Cystic Fibrosis Patients. International Journal of Molecular Sciences. 2022; 23(20):12645. https://doi.org/10.3390/ijms232012645
Chicago/Turabian StyleArtini, Marco, Gianluca Vrenna, Marika Trecca, Vanessa Tuccio Guarna Assanti, Ersilia Vita Fiscarelli, Rosanna Papa, and Laura Selan. 2022. "Serratiopeptidase Affects the Physiology of Pseudomonas aeruginosa Isolates from Cystic Fibrosis Patients" International Journal of Molecular Sciences 23, no. 20: 12645. https://doi.org/10.3390/ijms232012645
APA StyleArtini, M., Vrenna, G., Trecca, M., Tuccio Guarna Assanti, V., Fiscarelli, E. V., Papa, R., & Selan, L. (2022). Serratiopeptidase Affects the Physiology of Pseudomonas aeruginosa Isolates from Cystic Fibrosis Patients. International Journal of Molecular Sciences, 23(20), 12645. https://doi.org/10.3390/ijms232012645

